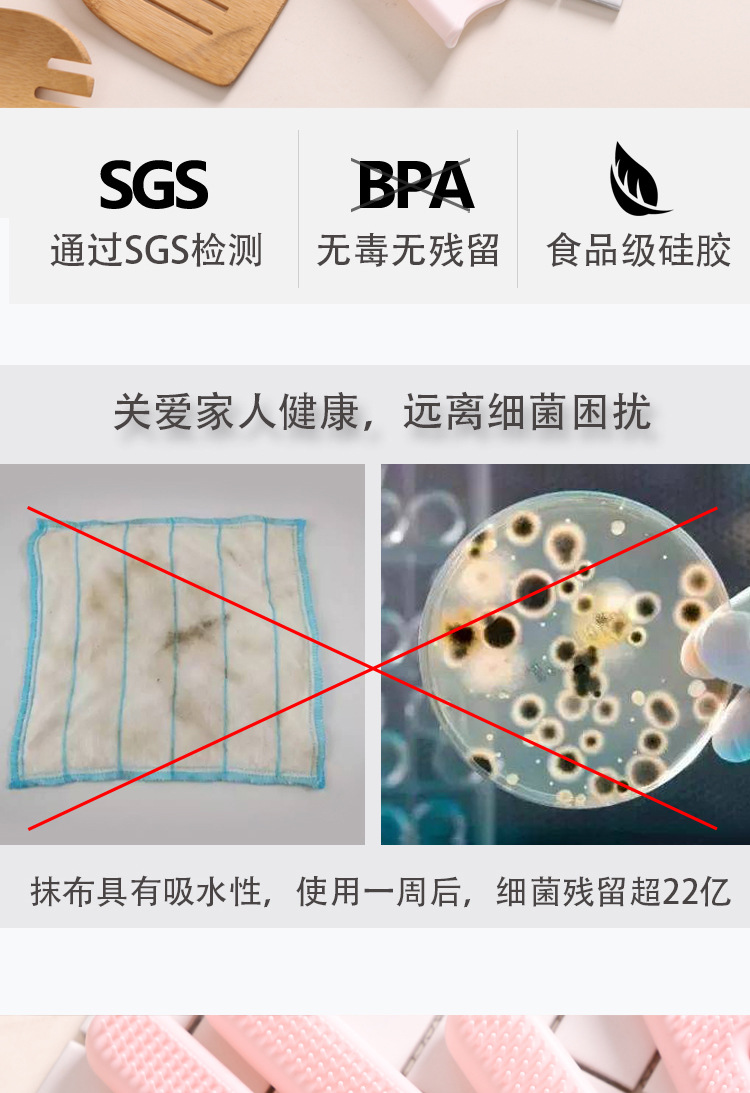
undefined

Search history
Clear allSearch by image
XDrag and drop an image here or upload an image
Max 5MB per image
UploadSign In | Join
X Email Mobile
| nordic blue: l | ¥14.01 | 986 set available |
|
| ice blue: m | ¥10.78 | 966 set available |
|
| flesh pink: s | ¥7.55 | 836 set available |
|
| ice blue: s | ¥7.55 | 889 set available |
|
| flesh pink: l | ¥14.01 | 980 set available |
|
| flesh pink: m | ¥10.78 | 977 set available |
|
| nordic blue: s | ¥7.55 | 918 set available |
|
| hibiscus purple: s | ¥7.55 | 915 set available |
|
| hibiscus purple: m | ¥10.78 | 983 set available |
|
| hibiscus purple: l | ¥14.01 | 994 set available |
|
| ice blue: l | ¥14.01 | 996 set available |
|
| nordic blue: m | ¥10.78 | 971 set available |
|
A new item has been added to your Shopping Cart. You now have items in your Shopping Cart.

Update time:
TOP